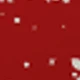
Rojo

- Video













2 piezas Funda de cojín de poliéster con diseño de árbol de Navidad rojo, funda de cojín para sofá (no incluye el relleno del cojín)
SKU: sf25051469933223035
Desde
$21.672
Color:Rojo

Talla
40*40
45*45
50*50
55*55
60*60
Más información
Seguridad en las compras
Pagos seguros
Protección de privacidad